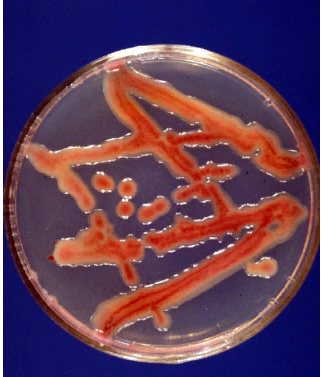

Рост бактериальной культуры
Bacterial culture growth
Статья из разделов: СловарьТерминыБактерии
Рост бактериальной культуры – увеличение числа бактериальных клеток в результате их роста и размножения. Характер роста культуры зависит от биологии конкретного вида бактерий и условий окружающей среды. Бактериальные культуры характеризуются культуральными признаками, которые выявляют по особенности их роста на различных жидких и плотных питательных средах. Каждый вид образует на плотных средах колонии определенного размера и соответствующей формы.
(c) Справочник AgroXXI